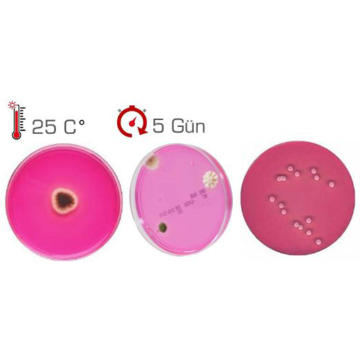
Across Bio 530370B Rose Bengal Agar + Cholamphenicol + Dichloran (DRBC Agar) 500 gr

0 -
Across Bio 530370B Rose Bengal Agar + Cholamphenicol + Dichloran (DRBC Agar) 500 gr
3.264,75 TL + VAT
%7
3.643,46 TL
3.917,69 TL
| Across Bio 530370B Rose Bengal Agar + Cholamphenicol + Dichloran (DRBC Agar) 500 gr |
|
In vitro (canlı hücre dışında) koşullarda yapılan mikrobiyolojik analizler için kullanır. Araştırılmak istenen hücreleri ve sporları tespit edebilmek için yeterince seçici besiyerleridir. Across Bio ürünleri, kolonilerin mikroskobik inceleme ile kolayca tanımlanıp araştırılması için yeterli alt yapıyı sağlar.
Genel kullanım amaçlı, gıda ve çevre örneklerindeki mikroorganizmalarda, klinik mikrobiyoloji uygulamalarında son derece yetkin ve tanısal besiyerleridir.
ISO, EP ve USP standartlarına uygundurlar.
|